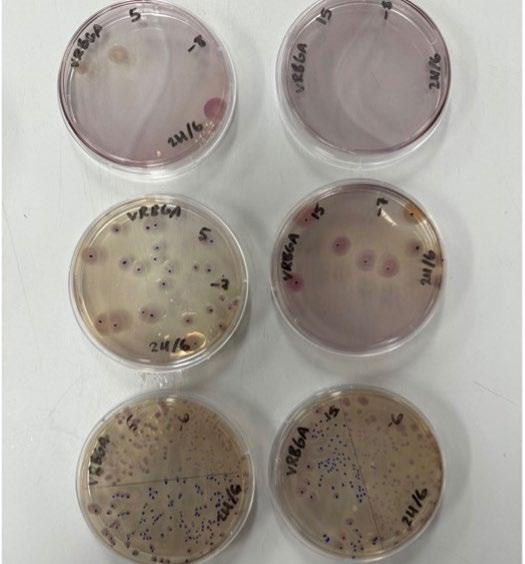

HSC SHOWCASE
Featuring 2024 HSC Major Works from Drama, Textiles, Visual Arts, Design and Technology, Science Extension. Extension 2 English and Music


“Anything can happen. That’s the beauty of creating...”
Welcome Message from Mr Paul
Horvath, Head of Teaching and Learning
There is something special about Major Works for the Higher School Certificate. From the opening conversations and brainstorms on ideas to those last, frantic minutes on the day of submission … and everything in between … a Major Work challenges students to sustain an idea, overcome adversity, work to deadlines and maintain strong relationships all whilst harbouring creativity, ingenuity and innovation.
And this year’s HSC Major Work students at Snowy Mountains Grammar certainly experienced all of this, and more.
Over the following pages you will read about the inspiration, the struggles and the realisation of projects in Drama, Textiles, Visual Arts, Design and Technology, Science Extension. Extension 2 English and Music. These are works produced by students who we are immensely proud of for their resilience and grit.
It is a determination that characterises how we undertake the HSC journey and one that cannot happen without the support, guidance and mentoring of our teachers. Their devotion, encouraging, expert guidance and, above all, their authentic care for our students is a remarkable feature of our school community.
Congratulations to all.


g I r LS WILL BE g I r LS (Group)
By Mia Andrews, Billie Bressington, Paisley Coulson, Ruby Freeburn, Tippi Wieland, Emily Willsmer
We were all hearing of the increasing amounts of domestic and sexual violence in Australia and concerned about younger peers trivialising these issues by making jokes. We became passionate about shedding light onto the importance of sisterhood, and the power we have in listening to and supporting one another.

T HE B Wor D (Individual)
By Dolores Whiskeyman
Performed by Billie Bressington
I chose this monologue because, looking for a comedic piece I enjoyed the intensity of the character, Edna. I thoroughly enjoyed the process of developing this character as she battles the battles of men vs women.

T HE Ha PPIEST Day of My L I f
E (Individual)
By Pete Malicki
Performed by Emily Willsmer
When attempting to find a monologue, I found myself leaning towards a comedic piece. However, I also wanted to challenge myself practically and delve into a character so different from myself. Once I read The Happiest Day of My Life I knew this the piece for me.

oLE anna (Individual)
From Oleanna by David Mamet
Performed by Paisley Coulson
When I first read an excerpt from the script, I was immediately moved and inspired by Carol’s story, her strength, and character. I could relate to her strength and determination to stand up for her convictions. I really enjoyed the process of developing this monologue, and am proud of my achievements.

co ST u ME DESI gn
Ruby Freeburn
I chose costume design for my Individual Presentation in HSC Drama because I have always loved creating artistic designs. While it was enjoyable, it also came with challenges. I selected four characters from Stories in the Dark so that, through research, I could contrast the experiences of war-torn refugees while exploring some fierce and magical fairytale characters.



a LIZE STE gga LL

My costume brings Ancient Greece to life, weaving together the fierce intellect of Athena and the wild, untamed power of Poseidon. A fitted bodice flows into a full-circle skirt with striking bustle accents, capturing both strength and unpredictability. The bold neckline commands attention, while the flowing fabric mirrors the ocean’s restless energy. Shades of deep ocean blue and touches of gold shimmer like the gods themselves. Inspired by the genius of Al Ali, this piece isn’t just a garment—it’s a story, a celebration of myth, made for those who dare to embody the power of legends.


JESSI ca HELLyar
For my HSC Major Works project, I wanted to create not only a gown but something deeply meaningful to me. The butterflies and flowers on my dress symbolize my late grandmother. When she passed, we placed flowers on her grave, and butterflies swarmed around. Butterflies hold great symbolism for my family, as they represent my grandmother watching over us.
The rest of the dress was inspired by a Disney princess, an idea rooted in my childhood love for Disney princesses. I felt I owed it to my younger self to feel like a princess once again—to forget the complications of growing up and play dress-up one more time.

gI f T T o S T rang E r S , My SEL f (no T you)
Lace Baker
Digital Drawings
I like to think of my suite, Gifts to Strangers, Myself, and (Not You), as an exploration of my strengths as an artist. I don’t wish to sell my tragedies (not here anyways); not with you. No, what textures my works is the joy I bring to those I hold dear. In their creativity, their unorthodox heroes and layered characters, we share this gift. The smiles I bring coalesce to form all I could ever desire in my creative expression.

T HE S T ory of a LI f E
Billie Bressington
Mixed Media
In my series The Story of a Life, I delve into the rich history of my Nonna and her story travelling from her home in Poggioreale, Sicily to Sydney, Australia in 1953. The tragedy of her mother’s suicide in 1977 along with the catastrophic earthquake in 1968. My series consists of watercolours, photography, Lino prints and two installations of an antique suitcase and a piece of timber with “Vita” illustrated with nautical rope. I incorporated two photos of my Nonna, her two brothers and mother from Poggioreale and the second one once arriving in Australia. My Nonna was only left with five pieces of jewellery, the two photographs, a perfume vase and a duvet and pillow that was personally hand embroidered by my Great grandmother, Vita; meaning life.

fE ar WH o you ar E
Paisley Coulson
Mixed Media
My artwork, Fear Who You Are explores the experiences of LGBTQ+ identity. Within the triptych, the work follows elements of identity –questioning identity, queer culture, and rejection. I used a large range of mediums for my work, as I enjoy creating chaos and layers within artworks. These mediums involve chalk, spray paint, acrylic paint, Artline pens, and charcoal. My work was heavily inspired by artists like Jean-Michel Basquiat and Paul Yorke.

aMPH ora fa MI g LI a
Sienna Davies
Lino Print on Stonehenge Paper
My upbringing was a merge of Italian and Australian culture, inspired by the art making from my Nonna, Mum and Dad and their different ways to express their art. I connected with Lino printing due to its tactile and hands-on nature, offering creative control and a unique aesthetic. The bold, high-contrast images produced by this technique can appeal to those who appreciate simplicity and the power of strong lines and shapes. Additionally, Lino printing’s reproducibility allows for multiple prints from a single design, making it an accessible medium that carries historical and cultural significance. Creating prints that connect to all sides of my family really shows the journey my family experienced.

Sno W y Moun Ta I n S TH roug H M y E y ES
Ruby Freeburn
Photography and Lino prints
Snowy Mountains is captured through my Lino prints and Photography. My artwork was strongly inspired by my upbringing being in the Snowy Mountains, and the impact it had on my life, this being capturing all the memories around the region, going camping, swimming, skiing etc. The Snowy Mountains inspired me to create my piece evolving around here as it is such a beautiful place with lots of meaning, the colours, wildlife and experinces here are amazing, and I’m so glad I could create such a meaningful piece to me. The photographs capture Geehi, Deadhorse Gap, Thredbo and Jindabyne showing the surrounding of my home town. The Lino Prints capture huts around the Snowy Mountain region, Geehi, Moonah and Tomgroggin.

Soc IET y K ILLED THE T EE nag E r
Jessica Hellyar Acrylic, Canvas Perspex
“We’re teenagers and society has killed us”. This quote is from Jess Addario’s Society Killed the Teenager. This poem has profoundly influenced my work, these artworks explore the way I see society. The sudden changes, the need to fit in and how the media can control our thinking are the main themes I have explored across all four of my pieces. As much as we all think that we are different, the difference is not as big as you may think. I wanted to point out the truth, the behind the scenes of it all, using acrylic paint to create figurative abstract like technique to give off a dystopian like feel to create an atmosphere that can disturb and change one’s thinking.

rI c H Man’ S H o ME
Ayden Neyle Watercolour
Rich Man’s Home was strongly inspired by contemporary issues such as the housing crisis affecting many Australians’ lives and futures. My intention behind creating old Australian suburban houses that were commonly built after the war using materials such as asbestos. What once were considered easy to acquire humble homes to house the masses are now luxury items only afforded to the wealthy.

T HE L o ST oLy MPI c T I c KET
Cassandra Nicholls Photography and Lino Prints
The Lost Olympic Ticket is inspired by my love for skiing, and my body of work reflects my journey leading up to the Youth Olympics in the final months of 2023. Unfortunately, my path took a drastic turn during training when I suffered a severe fall, resulting in major knee damage that required a full reconstruction. This injury prevented me from competing in the Youth Olympics. I turned to photography to convey my experience visually, using it as a crucial element in my major. Photography serves as a versatile tool for inspiration, reference, and creative exploration, allowing me to document my journey. By combining photography with other art forms, such as lino prints, I can deepen the meaning of my work through a unique, expressive perspective.

So LIT u DE I n S ILE nc E
Jesse Paske
Photography
In my series Solitude in Silence, I explore the profound stillness found in the mountains, captured through the lens of black and white photography. Solitude, for me, is not merely the absence of people but a space where the essence of nature speaks most clearly. The decision to present these images in black and white stems from a desire to strip away distractions and allow the purity of the mountain forms to emerge unadorned. The Snowy Mountains have always been an important aspect of my life, and my series of photographs aim to reveal the textures, contrasts, and subtle gradations that speak to the mountains’ inherent solitude.

u nrav ELLI ng of Innoc E nc E
Sarah Rankin Textiles
Unravelling of Innocence is a collection that explores the loss of innocence and the complex transition from girlhood to womanhood. Using stitching — a traditionally feminine craft — I combine delicate, orderly embroidery with loose, chaotic threads to represent the disruption of youth. The works incorporate text that expresses the darker emotions and struggles of growing up, revealing the internal conflict of this change. By reimagining embroidery beyond its domestic roots, I aim to highlight the resilience and beauty within the challenges of coming of age, using the art of stitching as a narrative tool for personal transformation.


My THI ca L Ma D n ESS
Riannah Kell
Drawing
Mythical Madness was born from my deep fascination with the world of mythical creatures. Through my artwork, I aimed to open a window into their enchanting realms and breathe life into their legends. The griffin, or gryphon, stands as a powerful symbol in my work—a majestic creature with the body, hind legs, and tail of a lion and the wings, talons, and head of an eagle. Revered for its symbolism of power, wealth, courage, and prestige, the griffin embodies the essence of strength and nobility. Similarly, the ninetailed fox of the Qin Dynasty, known as an auspicious emblem, represents peace and prosperity. In contrast, the skull-headed fox reflects the cyclical nature of life and the inevitability of change, capturing the balance between life, death, and transformation. The hippocampus, with its blend of the horse and sea creature, symbolises the duality of commerce and seafaring—a fusion of land and oceanic adventure. Through drawing, I seek to unveil the beauty of these mythical beings, using light and shadow to create an atmosphere that enhances their dramatic and mystical qualities. Each piece strives to evoke a sense of wonder, allowing viewers to step into a world where these extraordinary creatures reign supreme.

W ISH you WE r E HE r E
Tippi Wieland Photography
In the depths of loss and amidst the tumultuous waves of grief, there exists a profound journey of self-discovery and resilience. My photography series delves into the narrative of my brother, Ned, whose poignant experience of losing a friend to mental health struggles ignited within him an unwavering commitment to raising awareness and fostering healing through the embrace of water. By photographing Ned in various locations, I aim to convey the sense of pilgrimage and homage inherent in his journey. Each spot evokes memories of moments shared with his friend, steeped in the beauty and solace of the water. In essence, Ned is metaphorically taking his friend on a journey to places they loved, honouring their bond and the role water played in their lives. My photography serves as a contemporary iteration of the age-old impulse to bear witness to the human experience, offering a nuanced portrayal of resilience and healing in the face of adversity.

M EM or IES of Mu M
Emily Willsmer Watercolour Painting
Memories of Mum is an intimate exploration of loss, grief, and reflection, captured through the delicate and fluid medium of watercolour. This piece emerged from a profoundly personal space following the tragic loss of my mother in a car crash, a moment that has irrevocably shaped my world and my art. Watercolour, with its delicate and transient qualities, seemed to embody the fragility and impermanence of memory itself. The subtle interplay of colours reflects the bittersweet essence of remembrance—where sorrow and warmth intertwine, and where moments of clarity are often surrounded by the soft blur of longing. The painting is a meditation on the ways we carry our loved ones with us, even as we navigate the profound silence left in their absence. It is both a personal requiem and a universal reflection on how we cope with the intangible but deeply felt connections to those we have lost. “Memories of Mum” is more than a tribute; it is a space for both me and the viewer to find comfort and meaning in the enduring presence of memory. My work invites you to journey with me into the quiet realms of remembrance, where love and loss coexist in a delicate balance.

a S c E n D – fL oo D Pr E v E n TI on LI f TI ng S y STEM
Alize Steggal

My motivation to design a lifting system for tiny homes in flood-prone areas stems from witnessing the devastating effects of floods in both rural and urban Australia. Flooding not only destroys homes and financial assets but also endangers human lives, creating a serious challenge for those living in vulnerable regions. As a student of design and geography in a rural area, I am deeply committed to protecting the natural world while ensuring that society has safe, habitable spaces. My passion for architecture, combined with my design education, drove me to develop an innovative housing solution that can withstand the effects of floods, particularly for rural communities. The severe flooding in late 2023 and into the summer of 2024 in Australia has highlighted the ongoing financial strain on rural communities, where the cost of renovating or rebuilding is a recurring challenge. My concept offers a secure and adaptable housing system that would allow homes in flood-prone areas to remain safe and habitable, providing longterm relief to these affected communities.


g u M nu T S E n S ory Po D
Elise Philpott

My motivation for this project was to design a solution to the difficulties which students diagnosed with ASD experience in the classroom. Throughout my schooling experience, I have observed many scenarios where students with symptoms of ASD are simply thought to have ‘poor behaviour’, leading to numerous teacher frustrations due to the learning difficulties of the student. This negatively influences young people with ASD, as they are not able to engage in all classroom activities to maximise their learning. The development of a product that supports ASD students to reach their full potential in a mainstream classroom environment rather than needing to attend a Special School is important to address in a modern and progressive classroom. Additionally, implementation of this concept Australia-wide will raise awareness of the symptoms and classroom difficulties associated with ASD, promoting a more accepting school environment for those with this developmental disabilitiy. This will allow students with ASD to remain in a standard classroom environment with minimised learning issues. This product will provide a safe space for students to retreat to when feeling overwhelmed, and enable them to take time to self-regulate without having to leave the classroom.



M I yag IS Wa X rE cyc LE r
Hamish Lingren

My motivation for this project centres around my love for snowsports. As someone who owns a “quiver” of snowboards, I understand the importance of maintaining the base of the ski and/or board, not just for performance, but also to extend its lifespan. When maintaining skiing equipment, ski wax is largely utilised to keep the ski/snowboard gliding on snow. However, over the 2023 ski season, I noticed a concerning trend with my wax: the frequent disposal of it after scraping it off the board. I managed to gather a bucket full of wax scrapings just from a season –from only one person. Thinking about it, Ski wax is essential, but if this is an issue for me, how much could it impact the whole ski industry? As a designer, I was motivated to fill this gap to ensure that ski wax can have a second life after being put on a snowboard and scraped off. My design brief for this project was to design a product for the snowsports market that will remelt used wax, allowing for an extension of lifespan for waxes. This offers a second life to wax after being scraped off the base of a snowboard and/or skis. The product is primarily targeted towards the at-home waxing market, focusing specifically on people who frequently use ski wax to maintain their equipment throughout the snow season. The life cycle of ski wax is short; it is formulated, put into a mould, sold, and then is applied to a board/ski. After the initial application it is scraped off, it is discarded -this product aims to extend the life cycle of waxes after being scraped offwhile being as convenient for the consumer as possible. Miyagis Wax Recycler was designed to easily be accessible for the user to reuse their ski waxes.


LM Too L Tray
Hamish Schumack

The goal was to design a lamb marking tool tray that not only organises all necessary tools but also keeps them sanitised by holding a disinfectant solution, thereby enhancing hygiene and safety during the lamb marking process. Having grown up on a sheep farm, I’ve seen various disorganised methods, such as using buckets or drums for tool storage, which can lead to accidents and unsanitary conditions. NSW Local Land Services stress the importance of clean tools to prevent infections, recommending soaking instruments in disinfectant and cleaning them frequently, but they don’t specify a suitable container. Drawing inspiration from organised tool storage in other professions like mechanics and surgeons, this design aims to fill that gap with a dedicated tray that ensures each tool has its place and remains in the disinfectant mix when not in use. This will improve safety for handlers and welfare for the sheep by maintaining a higher standard of hygiene.


r oc K on – rE cyc LED E XPEDITI on
Sarah Rankin Trail Mat

Rock On is an upcycled sit mat it is designed with sustainability and functionality at its core, repurposing discarded materials to create a practical and eco-friendly seating solution for hikers. Made primarily from upcycled nylon tents, the sit mat embodies a commitment to reducing waste and giving new life to used materials. It’s lightweight and foldable design makes it easy to carry, while the durable, water-resistant fabric ensures comfort and protection from damp or rough surfaces. The mat’s compact size allows it to fit effortlessly into any backpack, promoting convenience for hikers and campers of all abilities. By transforming waste into a versatile, everyday outdoor essential, this sit mat encourages a more sustainable approach to exploring nature, proving that comfort and environmental consciousness can go hand in hand.


D ESI gn for THE M I n D - r o LLE r
Sienna Davies Natural Bespoke Fidgets

Life at my old school was fantastic for a teenager without any learning needs. For my friend Will, though, it was a different situation. His learning was compromised because there were no age-appropriate toys or gadgets that met his needs as a neurodivergent student. He craved distractions and would fidget with things in the classroom, which created noise that distracted the rest of the class and drew unwanted attention, causing him even more distress. Will deserved to have solutions to his problems as a learner. I designed this fidget toy with that in mind. It reconnects you with nature through its simple, organic form. Made from sustainably sourced wood, it offers a calming tactile experience with smooth, polished edges and a natural texture. It encourages focus and relaxation, especially for teenagers like Will who manage stress by fidgeting. Considering sustainability, my minimalist design ensures that the toy’s entire life cycle has a minimal environmental impact. It’s more than just a toy, it’s a mindfulness tool that balances personal well-being with a respect for the earth.

T HE Huc KIE
Thomas Smith

The Huckie is a project that stems directly from my experiences and passion as a park skier. Over the past year, I’ve poured my heart into mastering tricks like popping and 360s, only to find my progress frequently interrupted by crashes, some of which led to painful head injuries. These setbacks, combined with witnessing similar accidents among fellow skiers—sometimes requiring urgent intervention from ski patrol or even helicopter evacuations—ignited my determination to create a solution. I envisioned the Huckie as a revolutionary mini airbag system that can be worn as a hood or attached to a helmet, offering comprehensive protection for both the front and back of the head. The system features a small air canister that inflates the airbag rapidly when activated by a pull cord or button, providing crucial cushioning without obstructing vision or impeding movement. My aim with The Huckie is to enhance skier safety while allowing them to fully enjoy the thrill of the sport. By transforming my personal challenges and insights into a practical solution, I hope to offer a tool that helps skiers avoid serious injuries and continue pushing their limits with confidence.


TH roug H M y E y ES
Jessica Hellyr

I am deeply passionate about fostering empathy, understanding, and inclusion for individuals with learning disabilities, and I believe that the most effective way to achieve this is by starting with children. Children have a natural curiosity and openness to learning, which makes them the perfect audience to begin a conversation about neurodiversity. My goal is to educate younger generations about learning disabilities such as Dyslexia, ADHD, and Autism Spectrum Disorder. I want them to understand that these conditions don’t define a person’s intelligence or worth; instead, they represent unique ways in which some individuals process information. My goal for this project was to design a children’s book, using anaglyph technology, to help children and adults to understand the difficulties some of their peers may face in day-to-day life with learning disabilities such as Dyslexia, ADHD, and Autism.

T HE Eff E c TS of c r E aTI n E on In TESTI na L M I crof L ora
Jack Perkins
Gut health is an increasing focus of medical science given its far-reaching impacts on wellbeing, with studies finding increasing influences on it. Creatine is a common exercise supplement with clinically proven benefits to performance as well as recent suggestions of an effect of gastrointestinal disease and microbiome composition. This report examines the growth of representative gut bacteria under the influence of different creatine doses to determine if creatine directly promotes or inhibits growth of gut bacteria. Using optical density measurements and statistical analysis of the results and colony counts, it was found that gut bacteria both does and doesn’t have significant differences in growth rates in the presence of creatine, indicating that creatine gastrointestinal effects must be follow further experimentation.

T HE a n TIB ac TE r I a L Pro PE r TIES of Hon E y I n THE Monaro rE g I on
Elise Philpott
This investigation aimed to determine if honey grown locally in the Monaro Region has capabilities to inhibit microbial growth. This was executed by collecting samples of raw, local honey, and testing for its antibacterial properties against a gram-positive bacterium (E. faecium) and a gram-negative bacterium (E. coli). Growth curves were conducted by taking measurements of the optical density of the bacterial culture at 530nm at regular intervals, and analysing results. From this, statistical significance suggested that local honey from the Monaro Region is successful as an antibacterial agent against grampositive bacteria (E. faecium), with a p-value of less than 0.0001 giving a 95% confidence interval. However, this trend was less pronounced when tested against gram-negative bacteria (E. coli). Following this test, a bacterial culture containing honey and soil samples native to the Snowy Monaro Region was cultivated, diluted, and added to agar plates with an aerobic, anerobic, and fungal growth promoting conditions. Bacteria was grown over 5 days, and plate counts conducted to determine the effects of different dilutions of honey on the growth of bacteria. No trends were observed in this test to indicate that honey local to the Monaro Region has antibacterial properties, though the antibacterial effect could have been masked by the confluent growth of bacteria responding to or contained within, the honey added.

v o LTag E Po TE n TI a L of Hou SEH o LD Wa STE I n M I cro BI a L f u EL cELLS
Hamish Lindgren
This investigation aimed to explore the use of household compost waste as a substrate to affect the voltage output of electricity-generating microbes in a microbial fuel cell. This was analysed through two different environments: compost and alpine lithosols. Samples were placed in different containers and supplied with Iron and Acetate to evaluate growth and placed in a water bath to incubate. Through outsourced DNA sequencing, the result was that acetate and iron increased the growth of certain electricity-generating bacteria, and compost provided the extra organic material to supply a more consistent, and higher voltage generation. Geobacter was found in a sample with iron substrates added to lithosol, and this was the highest voltage generation of the series. It was determined that compost had a positive effect on voltage generation, as it maintained the highest average voltage across all samples. Thus, the use of household compost waste was successfully evaluated throughout the investigation.

u n TETHE r ED Bon ES
Elliana Dickerson
When wandering the silent corridors of our mind, emotions and thoughts intertwine; they feed the never-ending hunger for something more, something bigger than is currently before. The piece Untethered Bones confronts intimidating societal topics headon in harrowing expressions. The suite of free-verse poetry is one of caution, directed for audiences of a mature level as it confronts heavy topics of domestic abuse and suicide. This piece was written to confront the daunting truths of domestic violence, in hopes that survivors themselves feel comforted in their mindscapes. It delves deeply into the depths of human emotion, but ones that must be brought to the light of acknowledgement; one is not just a victim, but also a survivor.
T HE a r TH ur I an L E g E n D
Thomas Smith
Dive into the rich tapestry of the King Arthur legends with this in-depth Major Work, meticulously crafted to illuminate the intersection of myth and history. This project offers a nuanced analysis of Arthurian legends, bridging the gap between medieval myth and historical reality. It examines the origins and evolution of these timeless stories, drawing on primary sources like Geoffrey of Monmouth’s “History of the Kings of Britain” and contemporary scholarly interpretations. Through rigorous research and critical analysis, this work unveils the historical and literary contexts that shaped the Arthurian tales, revealing their enduring relevance. It explores the legends’ transformation from medieval to modern times, highlighting how they continue to reflect universal themes of leadership, honour, and morality. Engaging with both serious and whimsical adaptations, including Monty Python and the Holy Grail and The Sword in the Stone, the project underscores the legends’ impact on contemporary culture. This Major Work is a testament to the ongoing dialogue between myth and history, offering readers a comprehensive and engaging exploration of the Arthurian legends’ origins and their significance in today’s world.
I
T Wa S
no
T I n S an IT y; IT Wa S a B y SM a L STaTE of LIME r E nc E
Cora Whitehead
The suite “It was not insanity; it was an abysmal state of limerence” explores the complexities of love, substance abuse, and the human psyche, blending dark romanticism with themes of addiction. It offers a lens into the human psyche’s darker corners, fostering empathy and understanding. Inspired by poets like Emily Dickinson and Kenneth Slessor, I sought to capture the unpredictable nature of emotions and the struggle to cope with them, particularly in youth. The suite’s free verse structure reflects this unpredictability, while motifs such as “glass” and “burning throat” symbolise the intense experience of grappling with emotions. Vivid metaphors reflect the rawness of youth and heartache, inviting the audience to reflect on their own experiences of love, loss, and coping. By incorporating musical lyrics, I aimed to convey the layered nature of these experiences, ultimately demonstrating how coping through substance use deepens rather than alleviates emotional pain.
Lac E Ba KE r - P I ano
Twilight (Grant Arnold)
The Princess (AMEB)
On the Champs Elysees (W. Gillock)
Eleanor Rigby (The Beatles)
I enjoy the melodies that the piano can create and being able to learn how to play the piano has been very rewarding.

a J Br I n KM an - D ru MS
Rosanna (Toto)
Stairway to Heaven (Led Zeppelin)
Smells Like Teen Spirit (Nirvana)
I really enjoy performing ‘Rosanna’ because it’s fun to play and was a challenge to learn.

Pa ISLE y c ou LS on - gu ITar
Ocean (John Butler)
Spanish Caravan (The Doors)
I Put a Spell on You (CCR)
Jungle (Tash Sultana)
When I played ‘Ocean’ for the first time, I immediately knew it was a song I wanted to learn and play for my HSC. Whenever I play this song, I think about memories I have attached with the ocean, like sunrise swims with my Dad. I love playing this song so much and am so proud of it.

g a B r IELL a f or M an - vo I c E /gu ITar
Requiem (from Dear Evan Hansen)
Foolish Child (The Northern Folk)
Travelling Soldier (The Chicks)
Black Horse and the Cherry Tree (KT Tunstall)
I have been developing my guitar, vocal and composition skills, performing and busking often. I have enjoyed learning to use a loop pedal, which I use in Black Horse and the Cherry Tree.
Travelling Soldier - I really like songs in the folk and country genres as they often have a strong storyline and emotion. This song is no different. I love how emotional it is, the first time I heard it I got teary. It has always been important to me that songs have a story or a purpose. The songs I write are the same; they all have a story and emotion attached.

I also like how it has high notes in the chorus which makes it more challenging. I am also playing the guitar using fingerpicking which adds a layer of difficulty.
E MILy W ILLSME r - vo I c E
Moon Song (Phoebe Bridgers)
Both Sides of the Moon (Celeste)
Don’t Know Why (Norah Jones)
My Mind (Yebba)
My Mind - I chose this piece for 2 reasons. The first its vocal technicality and difficulty, as the song includes lots of complicated riffs, and has a large vocal range from very low to high notes. The second reason is because of the song’s conceptual meaning. To me, this song is about all the stresses I have endured, and the powerful portrayal of them all in the single line “about to lose my mind”.

Staff Reflections
Dra M a
It’s been an honour to work with the HSC Drama students this year. They faced each new challenge of devising theatre as a group with commitment and resilience. As a group of six young women, they found the space to have a voice and chose to highlight incredibly important societal issues. Whilst working on their Individual Presentations and areas of study, this class consistently explored their scripts with both an open mind and a delightful sense of humour. They should be proud of their curiosity and creativity as it assisted them in achieving some outstanding major works.
Mrs Catherine Batson
vIS ua L a r TS
The Year 12 Visual Arts students have worked tirelessly over the past 12 months to produce outstanding bodies of work, each showcasing their unique creative voices. Throughout the year, I have seen each student evolve not only in their technical skills but also in their conceptual thinking as artists. They have supported one another in both the creation of their artworks and the study of art theory, demonstrating that the journey of creation is made all the richer when shared with others. It has been an absolute pleasure to work with such a talented and dedicated group of students. As they move forward into the next stages of their lives, I hope they carry their creative spirit with them and continue to explore and create in whatever form that may take.
Miss Alice Ham

D ESI gn an D T E c H no L ogy
Mentoring our eight Year 12 Design and Technology students through the design process this year has been a privilege. The breadth and depth of ideas that this group brought to the table were impressive. Designing at this level allowed the students to transcend the boundaries of the classroom, enabling them to dive deep into real-world problems they aimed to solve. What impressed me most while working with these talented young designers was their capacity to iterate and remain divergent in their thinking in order to find the best possible solution, despite the many design constraints they faced. Collaborating with them to realise their ideas was an incredibly rewarding experience.
Mr Scott Frize
Sc IE nc E E XTE n SI on
The 2024 Science Extension students gained valuable experience in the Scientific Method and further developed their critical thinking skills throughout the year. The subject was rewarding as students worked consistently on data collection and analysis. We are fortunate to have various pieces of equipment at SMGS that allow students to pursue projects in areas of interest, particularly microbiology, which was the focus for all students this year. The skills they developed during these projects will serve them well into the future.
Dr Darryl Nelson

Eng LISH E XTE n SI on 2
Over the course of the year, the Extension 2 English students have demonstrated significant growth as independent writers. They’ve refined their writing and research skills, developing a deeper understanding of their craft while tackling challenges like time management and writer’s block. Their perseverance and dedication have been key to producing engaging and polished Major Works.
Ms Amanda O’Brien
Mu SI c
The HSC Music 1 class of 2024 have been a delight to witness. Each student is at a different level of skill, knowledge and confidence and being able to watch them develop and support each other has been inspiring. Each of them has overcome their own fears of ‘not feeling good enough’ or ‘I cannot perform like them’. It is my hope that the confidence, maturity and grace they have experienced in the Music class will stay with them throughout all areas of their life.
Mrs Sue Sell
Snowy Mountains Grammar School wishes to acknowledge the teachers, staff, parents and friends of our Year 12 students - thank you for supporting them through this process.

www.smgs.nsw.edu.au